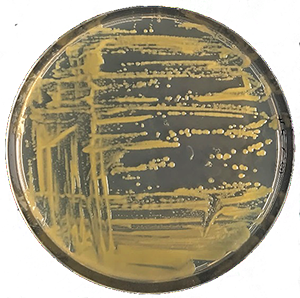
Xanthomonas campestris tenyészet táptalajon

Xantángumi (E415)
(Xanthan gum)
Source: Wikimedia commons

A xantánguminak a neve ellenére semmi köze sincs a klasszikus gumihoz, egy poliszacharidféleség, amit szőlőcukorból (glükózból) állítanak elő fermentációs úton a Xanthomonas campestris nevű mikroorganizmussal. Viszonylag új, az 1960-as években fedezték fel. Mivel kontrollált körülmények között állítják elő, szerkezete egységesebb, mint a növényekből izolált hasonló anyagok, használatának azonban határt szab viszonylag magasabb ára is. Még nagy mennyiség fogyasztása esetén sem találtak káros mellékhatást. Az EFSA újabb összefoglaló értékelése szerint a tápcsatornából nem szívódik fel, így rostanyagnak tekinthető, azonban a vastagbélben található bélbaktériumok egy csekély részét lebonthatják, az így keletkező egyszerűbb cukrok már felszívódhatnak.
Felhasználás: Már 1%-os mennyiségben is jelentősen növeli egy oldat viszkozitását. Nagyon gyakran találkozhatunk vele salátaöntetekben, készen árult szószokban, használják még levesporokban a kész leves sűrítésére s ajánlják (guargumival kombinálva) a gluténmentes lisztből készült sütemények, pékáruk tésztái textúrájának, tulajdonságainak javítására. Érdekes módon az olajipar is használja, nevezetesen a fúrásnál használt öblítőfolyadék reológiai, stb. tulajdonságainak javítására alkalmas.
Kémia: Molekulái a cellulózhoz hasonló hosszú glükózláncból álló poliszacharid, amihez még mannózból, glükuronsavból és piroszőlősavból álló oldallánc kapcsolódik. Mivel sav, sóként alkalmazzák. Kétvegyértékű fémekkel (Ca2+, Mg2+) alkotott sói fokozattan hajlamosak a zselésedésre.
Lásd még:
Magyar wikipédia
Tudatos vásárló
Az EFSA újra értékelése a xantángumiról (2014) (angol)
frissítve: 2021.6.1.